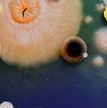
Microevo banner.jpg

Society events and meetings
At the Society, we provide a number of high quality events and meetings throughout the year. These generally focus on a specific microbiological theme and take place as smaller more intimate meetings, allowing for informal networking and dedicated time on one subject.
-
08
AMR in Focus - AMR surveillance to policy
8 September 2025
-
12
Microbial Genomics of Eukaryotes
12 September 2025
-
26
Journal of Medical Microbiology (JMM) Seminar - September 2025
26 September 2025 - Virtual - Virtual, online
Dr Lopes
-
06
Candida and Candidiasis 2025
06 Oct - 09 Oct - Berlin, Germany
-
20
AMR in Focus - Transitioning from academia to industry in AMR
20 October 2025
-
31
Journal of Medical Microbiology (JMM) Seminar - October 2025
31 October 2025 - Virtual - Virtual, online
Dr Kuehne
-
04
Microbiology Society Annual Meeting in Ireland 2025
04 Nov - 05 Nov
-
26
Understanding and predicting microbial evolutionary dynamics 2025
26 - 27 November 2025 - Liverpool, UK
Microbial diversity and evolution
September
October
November
-
25
Journal of Medical Microbiology (JMM) Seminar - July 2025
25 July 2025 - Virtual - Virtual, online
Prof Thuy Do
-
21
-
14
FEMS Micro 2025
14 Jul - 17 Jul
-
01
Microscience Microscopy Congress 2025 (mmc)
01 Jul - 03 Jul
-
27
Journal of Medical Microbiology (JMM) Seminar - June 2025
27 June 2025 - Virtual - Virtual, online
Prof James O'Gara
-
23
Early Career Summer Conference 2025
23 Jun - 24 Jun
-
30
Journal of Medical Microbiology (JMM) Seminar - May 2025
30 May 2025 - Virtual - Virtual, online
Dr. Jo Hobbs
-
13
Biofilms 11
13 - 15 May 2025 - Cardiff, UK
-
31
Annual Conference 2025
31 Mar - 03 Apr - Liverpool, UK